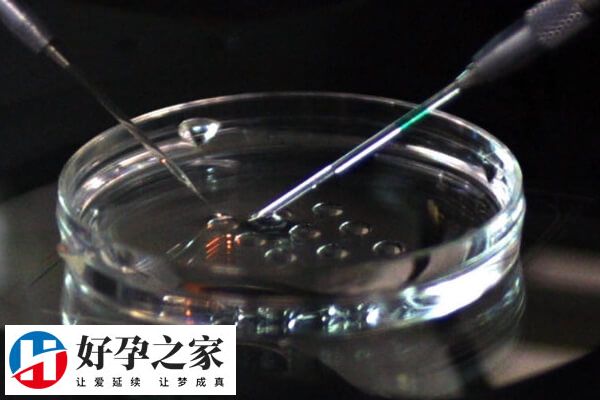
高龄做试管助孕有成功案例

高龄绝经女性可不可以做试管怀孕
作者:好孕之家
更新时间:2025-06-26
点击数:
试管婴儿临床上,针对高龄绝经女性来说,是可以通过试管婴儿怀孕的,不过由于自然绝经通常意味着卵巢内的卵泡已经耗尽,只有少数卵巢功能部分保留的高龄女性才能实现生育,而且通过试管技术成功妊娠的几率也比较低,大概在10%左右,具体还要根据个人情况进行综合判断。

高龄女性如何试管怀孕
如果高龄女性快要绝经了,或者是绝经了,那么卵巢功能和卵子质量都会发生不同程度的下降,所以促排卵是非常重要的,目前高龄女性常用短方案和超短方案2种促排卵方式,在促排后卵泡发育的具体情况确定最佳取卵时间。

另外,是子宫方面的原因,要说女性绝经后想要孩子怎么办,那就需要营造一个让胚胎能顺利发育的环境,所以子宫内膜的厚度要达标,标准范围为8-12mm,达不到标准须先采用黄体酮调理。
高龄绝经女性可以做试管怀孕
高龄女性,如是绝经后也是能通过试管婴儿技术助孕,但随着女性年龄在不断的增长,女性卵巢储备功能也会相应的有所下降。而绝经后的女性子宫环境也会不及她们年轻的时候,虽然现在没有明确规定绝经后做试管最大年龄,但是只要超过自然受孕年龄上限,基本就不适合做试管婴儿了,因为这很难成功。
根据目前的数据来看,尚有60岁做试管婴儿成功的案例,所以目前绝经试管婴儿年龄不能超过60岁,这也是目前试管婴儿技术助孕的极限年龄,而超过60岁的绝经女性,即使做试管成功,风险也非常高。




